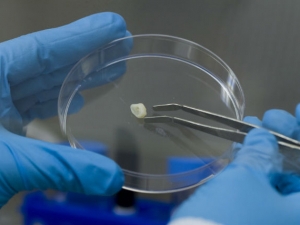

Uçağın sistemine sızdı, yönünü değiştirdi! 7 / 12 / 2016

ABD'li bir güvenlik araştırmacısı, bindiği yolcu uçağının elektronik sistemine sızarak havada yön değiştirmesini sağladığını öne sürdü. ABD'de yolcu uçaklarının siber saldırıya uğrayıp uğrayamayacağı tartışması sürerken, güvenlik araştırmacısı Chris Roberts, bindiği uçağı hafif bir şekilde yönünden saptırmayı başardığını öne sürdü. Yetkililer, Nisan ayında bindiği uçağa siber saldırı denemesi yapacağı yönünde tweet atan Roberts'ı uçaktan indirmişti. United Airlines, Roberts'ın gözaltına alınmasının ardından uçaklardaki bilgisayar sisteminde güvenlik açığı bulacak kişilere ödül vereceğini açıklamıştı. Roberts, en son açıklamasında bindiği uçağın eğlence sistemine sızdığını ve buradan uçağı çok az da olsa yönünden saptırmayı başardığını iddia etti. Roberts, uçakların irtifasının değiştirilebileceği gibi rotasından da saptırılabileceğini öne sürdü. KOKPİT SİSTEMİNE SIZDI FBI, çıkardığı arama kararında,...
Devamını okuTürkiye'de diş hekimleri her yıl yaklaşık 1 milyon diş çekiyor. 7 / 12 / 2016

YILDA 1 MİLYON DİŞ ÇEKİLİYOR Yetkililer Türkiye'de diş hekimleri her yıl yaklaşık 1 milyon diş çekiyor. 65 yaş üstündeki Türklerin yüzde 65'inin dişlerinin eksik. Eksik dişin estetik bozukluğun yanı sıra çene kemiği erimesi, diş kayması ve çene eklemi problemi gibi fonksiyonel sorunlara neden olduğuna dikkat çeliliyor, dental implant tedavisi ile bu sorunların önüne geçilebileceğini vurgululanıyor. "Çene kemiğinin çoğunu kaybetmiş hastalarda dahi ileri cerrahi teknikler yerine ön bölgelere 4 adet implant yerleştirerek sabit bir protez yapılma imkanı sağlanıyor". Tüm dünyada yaygın olarak kullanılan dental implant tedavisi Türkiye'de henüz yeterli ilgiyi görmüyor. Ülkemizde diş eksikliği olan hastaların sadece yüzde 4'üne implant tedavisi uygulanıyor. Dental implant hekimlere enerji veren bir alan omuş durumda. 90'lı yıllar implantı kemiğe kaynaştırma yıllarıydı. 2000 yıllarda kemiği...
Devamını okuTemizlik diyabeti tetikliyor mu ? 7 / 12 / 2016
İnsülin tedavisi gören diyabetik hastaların sayısı her geçen gün artıyor. Ancak bu hastalığın sebebi henüz bulunamadı. Diyabete sebep olan şeyler neler olabilir? Steril kentsel yaşam ve kimyasal yiyecekler bağışıklık sistemini zayıflatıyor mu? Bu soruların cevabını ilk önce Tip 1 diyabetin sık görüldüğü Helsinki’de arıyoruz. İrina Helsinkinin bir mahallesinde yaşıyor. Henüz 10 yaşındayken acilen hastaneye kaldırılmış : “Hala yaşıyor olmam büyük sanş. Çok kötüydüm, birkaç gün acil bölümünde yoğun bakımda tutuldum.” İrina’ya Tip 1 diyabet teşhisi konulmuş. O günden beri kan şekerini dengelemek için sık sık insülin enjeksiyonları yapmak durumunda. “Her öğünden sonra hızlı etkili enjeksiyon ve her akşam da uzun etkili enjeksiyon yapabilmem için elimin altında sürekli şırınga bulundurmak zorundayım.” ...
Devamını okuMIT öğrencileri yeni mikroskobik kamera ile algımızı açacak 7 / 12 / 2016
Massachusett Teknoloji Enstitüsü (MIT), araştırma görevlileri video kamera ile her bir pikseli salise salise kaydederek çıplak gözle görülmeyen hareketleri algılamamızı sağlayacak. Kare kare çekilmiş fotoğrafların bir bilgisayar programında bir araya getirilmesiyle ortaya çıkan görüntüler dünyanın aslında ne kadar hareketli ve esnek olduğunu gözler önüne serecek. MIT Yüksek Lisans öğrencisi Neal Wadhwa çalışmalarını anlattı: “Bunlar insanların hayatları boyunca hiç görmediği anlar ve biz onları şimdi görünür kılıyoruz. Kullandığımız mikroskop, çıplak gözle görülmeyecek kadar hızlı ve küçük titreşimleri video yoluyla bizlere aktarıyor.” Video için üretilen yeni yazılım her hareketi piksel piksel ekrana taşıyor. Sonuçlarsa ilham verici. Bir adamın yüzündeki kan dolaşımı ise aslında ne kadar renkli bireyler olduğumuzu bize hatırlatırken, yeni...
Devamını okuKüçük bir imalathane insan vücudunda bulunan yapay kemikleri sentetik halde üretiyor 7 / 12 / 2016
Sao Paulo’da bulunan küçük bir imalathane insan vücüdunda bulunan yapay kemikleri sentetik halde üretiyor. Ürünler tıp, dişçilik ve veteriner fakültelerinde verilen derslerde kullanılıyor. Doğal insan veya hayvan kemiklerinin taklitleri poliüretandan üretiliyor. Yapay kemikler tıp fakültesi öğrencilerinin eğitimleri yanında profesyoneller tarafından da kullanılıyor. Fabrika sahibi Paulo Costa e Silva ürünlerinin faydalarını açıkladı: “Yapay kemikler doktorların, işlerini daha hassas ve kontrollü yapmalarına, kendilerini geliştirmelerine ve böylece tıbbi hataların azalmasına yardımcı oluyor.” İmalathanede ürünler el işi kullanılarak üretiliyor. Kemikler bu sayede gerçeğe daha yakın oluyor. Ayrıca maliyetin ucuz olması için kemiklerin üretiminde geri dönüşümlü malzemeler kullanılıyor. Fabrikada yeni form ve malzeme kombinasyonları üretiminde...
Devamını okuJapon bilim insanları diş hekimliği okuyan öğrenciler için insansı robot geliştirdi. 7 / 12 / 2016
Japonya'da bilimadamları tarafından diş hekimliği okuyan öğrencilerin pratik yapmaları için kullanılmak üzere insansı robot geliştirildi.
Devamını okuİngiltere’de Ulusal Sağlık Servisi (NHS) 22 binden fazla diş hastasını yeniden kontrole çağırdı 7 / 12 / 2016

İngiltere’de Ulusal Sağlık Servisi (NHS) 22 binden fazla diş hastasını yeniden kontrole çağırdı. Nottinghamshire kentinde 32 yıldır hizmet veren Desmond D’Mello adlı diş hekiminin hastalarına kan yoluyla geçen virüs bulaştırmış olabileceği bildirildi. Diş hekimi, geçtiğimiz Haziran ayında hijyen konusunda ihmalkar davrandığı gerekçesiyle meslekten geçici olarak men edilmişti.
Devamını okuİlk kadın diş hekimimiz Ferdane Bozdoğan Erberk 7 / 12 / 2016

İlk kadın diş hekimimiz Ferdane Bozdoğan Erberk'tir. 1892: İlk Türk kadın romancı Fatma Aliye Hanım "Muhadarat" adlı ilk romanını kendi adıyla yayımladı. 1909: İlk Türk kadın siyasetçi Emine Semiye Hanım Osmanlı Demokrat Fırkası yönetim kuruluna seçildi. 1913: İlk kadın devlet memuru Bedriye Osman Hanım Telefon İdaresinde göreve başladı. 1913: Belkıs Şevket Hanım uçağa binen ilk Türk kadın unvanını aldı. 1920: İlk Türk kadın avukat Süreyya Ağaoğlu İstanbul Üniversitesi Hukuk Fakültesi'ne kaydoldu. 1920: İlk Türk kadın tiyatro sanatçısı Afife Jale İstanbul'da sahneye çıktı. 1921: Dr. Safiye Ali Almanya’da tıp eğitimini tamamlayarak ilk Türk kadın hekim olarak tarihimizdeki yerini aldı. 1922: Yedi kız öğrenci Tıbbiye'ye kayıt yaptırarak eğitime başladı. Haziran 1923: Nezihe Muhittin'in başkanlığında Kadınlar Halk Fırkası'nın kurulması girişiminde bulunuldu....
Devamını okuFiravunların diş hekimlerine ait 4200 yıllık mezar keşfedildi 7 / 12 / 2016

Mısır’da arkeologlar, eski Mısır uygarlığından kalma önemli bir anıt mezar keşfetti. Firavunların diş hekimlerine ait 4200 yıllık mezar, içeri girenlerin lanetleneceğini belirten hiyeroglif sayesinde bugüne kadar bozulmadan kalabilmiş. Keşfi yapan Mısırlı arkeologlar, 4200 yıllık mezarların, IV’üncü hanedan döneminden ve şimdiye dek bulunan en eski diş hekimi mezarı olduğunu belirtiyor. Bir diğer önemli olguysa, mezarların girişinde bulunan hiyeroglifler. Uzmanlar, girişteki hiyerogliflerde bulunan “Her kim mezarıma girerse, onu bir timsah ve bir yılan yer” yazısının hırsızları mezarlardan uzak tuttuğuna ve sayede bozulmadan bugüne gelebildiğini düşünüyor. Mezar duvarlarında dönemin günlük yaşamını anlatan hiyeroglifler de yer alıyor. Mısır Eski Eserler Yüksek Konseyi Başkanı Zahi Hawass, mezarların, dönemin tıp ve diş hekimlerinin yaşamlarına ışık tutacağına inanıyor: “Bu buluş bize diş hekimlerinin firavunlar için ne kadar...
Devamını okuEngelli arabasında yeni teknoloji 7 / 12 / 2016

Engellilerin işini daha da kolaylaştırmak için her geçen gün yeni bir teknoloji piyasaya çıkıyor. Bunlardan biri de çok işlevli engelli arabası. Merdiven çıkıyor, iniyor. Yükseliyor, alçalıyor, yatay pozisyona geliyor. Gerçekten muhteşem...
Devamını okuDiş Fırçasının Tarihçesi 7 / 12 / 2016

Diş fırçası, dişleri temizlemede kullanılan bir fırça türü.Normal bir diş fırçasında kırk adet kıl demeti ve her demette ortalama 40-50 adet kıl bulunmaktadır. Geliştirildikleri zamandan beridir diş fırçalarında genellikle sentetik fiber kullanılmaktadır fakat bazen kullanımında hayvan kıllarından da faydalanılmaktadır. Tarihçe Tarihin kaydedilmesinden önceki dönemlerden itibaren ağız temizliği için çeşitli önlemler alınmaktadır. Ağız temizliğindedal, kuş tüyü, hayvan kemikleri, kirpi dikenleri vb. araçlar kullanılmıştır. Tarihte bilinen ilk diş fırçası Eski Mısır'da MÖ 3000 yılında kalem boyunda ağaç dalları kullanılması ile yapılmıştır.Roma'da diş fırçaları doğal maddelerden yapılan kürdanlardan oluşmaktaydı. İslam dünyasında Salvadora persica (misvak) ağacının dalları ile diş fırçaları yapılmıştır. Misvakın kullanımı, kullanımına öncülük eden Hz. Muhammed S.A.S....
Devamını okuDiş dolgusu ve protez dişlerin yerini alabilecek bir bilimsel gelişme 7 / 12 / 2016
Harvard Üniversitesi‘nden bir grup araştırmacı diş dolgusu ve protez dişlerin yerini alabilecek bir bilimsel gelişmeye imza attılar. Araştırmacılar geliştirdikleri teknoloji ile dişleri yeniden büyütmeyi başardılar. Araştırmanın sonuçları sadece diş değil, kemik yenileme gibi alanların da önünü açabilir. Science Translational Medicine adlı bilimsel dergide yayınlanan makalede araştırmacılar, diş gövde yapısında yer alan hücreleri düşük güçte lazer ışınlarıyla tetikleyerek dentin isimli yapıyı yeniden oluşturmayı başardıklarını açıklamışlar. Dentin yapısına göz attığımızda diş minesinin altında ve kemik yapısında olduğunu söyleyebiliriz. Günümüze kadar diş hücrelerinin bulundukları ortamda yeniden yenilenmesi konusunda herhangi bir gelişme yoktu. Lazer yöntemiyle diş büyümesi yönteminden önce araştırmacılar gövde hücrelerini vücut ortamından izole edip belirli hücreleri geliştirebiliyorlardı. Eski yöntem...
Devamını okuDiş çürüklerinin tedavisinde yeni bir dönemin kapısını aralandı 7 / 12 / 2016

Fransız bilim insanları, diş çürüklerinin tedavisinde yeni bir dönemin kapısını araladı. Yeni yöntem, dolgu ve kanal tedavisini rafa kaldıracak. Yeni yöntem sayesinde, çürüyen diş kendini tedavi edip iyileşmiş olacak. İtalyan La Stampa gazetesinde çıkan habere göre, Paris'teki Ulusal Sağlık ve Tıbbi Araştırmalar Enstitüsünde görev yapan araştırmacılar, MSH (melanosit uyarıcı hormon) içeren bir jel ya da mikrofilm kullanarak çürük dişe müdahale ettiklerinde, dişin içindeki hücrelerin yenilendiğini gözlemledi. Fareler üzerinde yapılan testlerde, yöntemin uygulanmasından yaklaşık bir ay sonra çürüklerin iyileştiğini gören bilim adamları, bu yöntemle birçok insanın korkulu rüyası olan diş dolgularının ve kanal tedavilerinin ortadan kalkabileceğine işaret etti. Araştırmacılar, klinik testler tamamlanmadığı için bir süre daha piyasaya...
Devamını okuCerrahlara 3 boyutlu hologram desteği 7 / 12 / 2016
İsrail’de bir firma cerrahlara ameliyatlarda büyük kolaylık sağlayacak bir teknolojiyi hayata geçirdi. Bundan böyle doktorlar tıbbi bir işlem sırasında hastalarının anatomik yapılarını an be an, 3 boyutlu ve havaya yansıtılmış şekilde görebilecek. Şirket ayrıca ameliyatlar sırasında kullanılacak 3 boyutlu bir kalp hologramı üzerindeki klinik çalışmaların da başarıyla tamamlandığını açıkladı: “Sistem hastanın anatomisini çok gerçekçi bir şekilde yansıtıyor. Her şeyi görebiliyor hangi bölgede bulunduğunuzu rahatça anlayabiliyor ve içeride nelerin olup bittiğini eş zamanlı olarak gözlemleyebiliyorsunuz. Sistem sayesinde hastanızın anatomisini daha iyi anlayabilirsiniz.” Sistem, veri analizleri ve yoğun ışık projeksiyonları sayesinde çalışıyor. X ışınları, IMR ve ultrason görüntülerinden elde edilen ölçümler ve boyutlar bir hologram yaratıyor ve ardından özel bir cihaz...
Devamını okuCerrahi robotun hassas doku dikişi 7 / 12 / 2016
Cerrahi robotun hassas doku dikişi Günümüzde teknoloji oldukça ilerlemiş durumda. Hassas cerrahi operasyonlarda da artık robotlar kullanılmaya başladı. Bir fanus içerisindeki hassas dokuyu robotun dikişini izlerken, teknolojinin ne kadar geliştiğine bir kez daha tanıklık edeceksiniz.
Devamını okuCaretta carettaya '3D çene protezi' takıldı 7 / 12 / 2016
Pamukkale Üniversitesi (PAÜ) Deniz Kaplumbağaları Araştırma, Kurtarma ve Rehabilitasyon Merkezi'nde (DEKAMER) yaralı halde bulunan caretta carettaya, cerrahi operasyonla "3D çene protezi" takıldı. DEKAMER Müdürü Prof. Dr. Yakup Kaska, gazetecilere yaptığı açıklamada, AKUT ekipleri tarafından geçen yıl temmuz ayında yaralı olarak bulunan caretta carettanın Dalyan-İztuzu'ndaki merkeze getirilerek tedavi altında alındığını belirtti. TÜRKİYE TARİHE GEÇTİ "Akut-3" adı verilen caretta carettanın çenesinin büyük oranda parçalandığını, kendi başına beslenmesinin mümkün olmadığını gördüklerini anlatan Kaska, "Uygulanabilecek alternatif tedaviler ve yeni teknolojiler hakkında konuşurken 3D teknolojisinin işe yarayabileceği konusu gündeme geldi. Bu yeni teknoloji Akut-3'ün ait olduğu denizlere özgürce geri dönebilmesi ve bundan sonraki benzeri yaralanmalarda çözüm olabilmesi için...
Devamını okuBir diş hekiminden hoşlanıyorsanız dikkat edin! 7 / 12 / 2016

Bir diş hekiminden hoşlanıyorsanız dikkat edin yanlış kişiye gönlünüzü kaptırabilirsiniz. Çünkü diş hekimlerinin yüzde 81’i evli. Bu da tüm meslek grupları içerisinde en yüksek evlilik oranı. Birinin meslek seçimi size evli, bekar, boşanmış ya da halk tabiriyle ‘başı bağlı’ olup olmadığı konusunda fikir verebilir . Nüfus sayımı yoluyla elde edilen verilere göre son 50 yılın meslek ve buna bağlı evlilik ile boşanma bilgilerini bir tablo ile sunuyoruz. Buna göre sınır güvenliğini koruyan güvenlik görevlilerinin ‘dul’ kalma ihtimali en yüksek olan iş. Alçı ustasının evlenip aynı zamanda evinden ayrı yaşaması ihtimali bir hayli fazla. Bu kategoride ikinci sırada ordu mensupları bulunuyor. Sinema filmi teknisyeni olsanız nasıl bir hayat yaşarsınız? Veriler üzerinden konuşursak bekar bir hayat yaşarsınız. 1950 yılında mühendis, matematikçi ve...
Devamını oku11 km uzaktan Türkiye'ye diş tedavisine geliyorlar22 / 05 / 2015

Sağlık sektörünün her geçen yıl daha çok geliştiği Türkiye'ye yurtdışından talep sürekli artıyor. Bu kapsamda en çok tercih edilen sağlık dallarından birisi de diş tedavi hizmetleri. Sağlık Turizmini seçen hastalar, Avrupa ve ABD'de ayıracağı bütçenin neredeyse dörtte birini ayırarak, kendi ülkelerindeki hasta bekleme listelerinden kurtulup daha kaliteli ve kısa zamanda hizmet alarak tedavi oluyor. “SAĞLIK TURİZMİ DÖVİZ BASIYOR” Yurtdışındaki tedavi maliyetlerinin yüksekliği, diş tedavilerinde rotayı Türkiye'ye, özellikle İstanbul'a çevirdi. Ülkemizde akredite edilmiş uluslararası standartlara uygun kırkın üzerinde sağlık kuruluşu bulunuyor. Verilen hizmetin ucuz ve kaliteli oluşu, otelcilik hizmet kalitesinin yüksekliği, coğrafi konum ve teknolojik altyapı sağlamlığı Türkiye'yi sağlık turizminde önemli bir merkez haline getiriyor. Tüm bu veriler ışığında, Türkiye'ye son yıllarda Azerbaycan, Fransa, Belçika,...
Devamını okuPiller neden zaman içinde güç kaybediyor?22 / 05 / 2015

Satın aldığımız telefon veya laptop, ilk günlerinde çok güzel çalışıyorken, zaman geçtikçe pilleri artık tüm gün dayanamaz hale geliyor ve dijital cihazlarımızı sürekli şarja takılı çalıştırmak zorunda kalıyoruz. Bunun nedeni, cihazlarımızda kullanılan pillerin zaman içinde kapasitelerini kaybetmeleri ve daha az enerji depolayıp daha hızlı tüketmeleri. Peki ama piller niçin zamanla aşınıyor ve güç kaybediyorlar? Dizüstü cihazlarda kullanılan piller en fazla dört-beş sene içinde ömürlerini tüketiyorlar. Küçük boyutlu telefon pilleri ise iki üç sene içinde kullanılamaz hale dönüşüyorlar. Pillerin zayıflama süreci, ilk üretildikleri andan itibaren başlar. Zira piller kullandıkça aşınan mekanik yapıya değil, zamanla özelliğini kaybeden kimyasal yapıya sahip mekanizmalardır. Yani, ne yazık ki, çalışmadan bekleseler dahi zamanla güç kaybederler. Lityum-iyon pilleri çok nadir...
Devamını okuArtık onların biyonik kolları var22 / 05 / 2015
Avusturya’da geçirdikleri kazalar nedeniyle ellerini kullanamaz hale gelen üç hastaya biyonik el takıldı. Normal uzuvlarda olduğu gibi beyinden gelen sinyalleri algılayan mekanik eller, hastaların yaşamını büyük oranda iyileştiriyor. Ayrıca biyonik ellerin, el nakline göre daha az komplikasyonları olduğu belirtiliyor. Biyonik eli icat eden Viyana Üniversitesi’nden Prof. Oskar Aszmann, hala eli olan hastaların ne kadar onları 10,15 yıldır kullanamasalar da kesileceğini bilmelerinin kendileri için oldukça zorlu bir süreç olduğunu dile getiriyor. 14 yıl önce geçirdiği motosiklet kazasında sağ elinin işlevini tamamen yitirdiğini söyleyen 30 yaşındaki Milorid Marinkovic, biyonik eliyle oldukça mutlu olduğunu dile getiriyor: “2001 yılından bu yana hiçbir şey tutamıyordum. Şimdi ise sanki kaza hiç olmamış gibi. Benim bir parçam oldu. Gerçekten çok alıştım. Artık onsuz yaşayabileceğimi...
Devamını oku